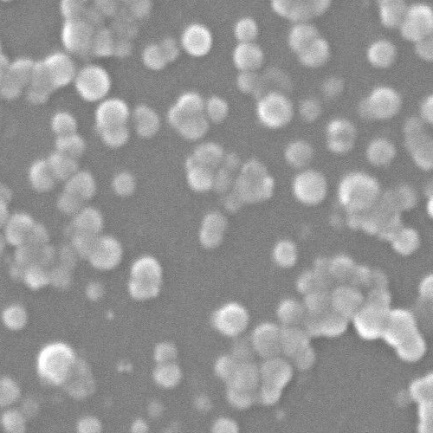

HMCuS的制备及其性能研究毕业论文
2020-03-04 08:54:15
摘 要
本课题合成了可作为药物载体的中空介孔硫化铜纳米粒(HMCuS NPs)。因为HMCuS NPs具有中空介孔结构并有很强的近红外吸收和高的光热转换效率,所以该粒子不仅可作为药物载体,还可以应用于光热治疗和光动力学治疗。
本文采用模板法合成了中空介孔的硫化铜纳米载体,研究了其光热转换性能。其主要内容如下:以水合肼为还原剂PVP-K30为分散剂,在碱性环境下,使氯化铜还原成氧化亚铜纳米球。再加入硫化钠或硫代乙酰胺硫化,生成中空介孔硫化铜纳米粒。并用DLS、氮气吸附、UV、SEM、EDS等手段对其进行了表征。
结果表明,该合成方法可以合成100纳米左右的中空介孔硫化铜纳米粒,并可以通过更换硫源、改变PVP的量、水合肼的量、硫化剂的量、硫化温度来调节产物的粒径大小。产物具有空心结构和大小合适的介孔,可作为药物载体,同时实验显示产物具有明显的光热转换特性,具有良好的研究前景。
关键词:中空介孔硫化铜;纳米载体;模板法;光热转换
Abstract
This topic has synthesized hollow mesoporous copper sulfide nanoparticles (HMCuS NPs) that can be used as drug carriers. Because HMCuS NPs have a hollow mesoporous structure and have strong near-infrared absorption and high photothermal conversion efficiency, the particles can be used not only as drug carriers but also in photothermo therapy and photodynamic therapy.
In this paper, hollow mesoporous copper sulfide nanocarriers were synthesized by the template method, and their photothermal conversion properties were studied. The main contents are as follows: Hydrazine hydrate is used as reducing agent PVP-K30 as dispersant, and under alkaline conditions, copper chloride is reduced to cuprous oxide nanospheres. Sulfur sulfide or thioacetamide was added for vulcanization to produce hollow mesoporous copper sulfide nanoparticles. It was characterized by DLS, nitrogen adsorption, UV, SEM and EDS.
The results show that the synthesis method can synthesize hollow mesoporous copper sulfide nano-particles of about 100 nanometers, and can adjust the particle size of the product by replacing the sulfur source, changing the amount of PVP, the amount of hydrazine hydrate, the amount of the sulfurizing agent, and the curing temperature. size. The product has hollow structure and mesopores with suitable size, which can be used as drug carrier. At the same time, the experiment shows that the product has obvious photothermal conversion properties and has good research prospects.
Key words: hollow mesoporous copper sulfide; nanocarrier; template method; photothermal conversion
目 录
第1章 绪 论 1
1.1药物控释系统 1
1.2靶向给药系统 1
1.3光热治疗和光动力学治疗 2
1.4纳米硫化铜的合成方法研究 2
1.5纳米硫化铜的研究现状 3
1.6 研究内容及意义 4
1.5.1 研究内容 4
1.5.2 研究意义 4
第2章 HMCuS的制备、工艺优化及表征 5
2.1试剂及仪器 5
2.2试剂及仪器 6
2.2.1 实验方案 6
2.2.2 HMCuS NPs的工艺优化 6
2.2.3 正交实验结果 9
2.2.4 HMCuS NPs的制备 12
2.3测试与表征 13
2.3.1 能谱分析(EDS)表征 13
2.3.2 纳米粒径分析 13
2.3.3 扫描电子显微镜(SEM)表征 14
2.3.4氮气吸附实验 14
2.3.5紫外光谱全波长扫描(UV) 15
2.4小结 16
第3章 HMCuS的光学性能研究 17
3.1样品的光学性能研究 17
3.2固含量对样品光热转换特性的影响 17
3.3功率对样品光热转换特性的影响 18
第4章 结 论 20
参考文献 21
致 谢 23
第1章 绪 论
癌症是全世界主要的公共卫生问题。在过去的几十年里,随着医疗技术的进步,各种癌症治疗方法已经得到开发和应用,包括手术,化疗,放疗,激素治疗和靶向等等。化疗是最常见的癌症治疗之一。与其他治疗方法相比,化疗具有操作简单,患者依从性好,治疗效果好等优点。尽管化疗在癌症治疗中发挥重要作用,但在临床应用中,大多数化疗药物通常在靶向性差或剂量限值毒性等方面存在问题[1]。因此,设计可实现肿瘤靶向和药物控释的局部给药系统成为改善化疗药物的关键问题之一。
1.1药物控释系统
药物在治疗疾病时往往会对正常组织造成伤害,同时,药物需要在体内发生代谢过程,药物只有在病灶达到一定浓度时才具有治疗效果,但会发生药物滞留在体内的现象。在这种情况下,太短的给药间隔会导致药物积累并可能产生毒副作用。但是,如果间隔太长,到达病灶的药物浓度太低,治疗效果不理想。因此,药物控制释放系统的设计目标是增加药物负载并实现定期,定量和控制药物释放[2-3]。其主要优点为:提高药物的利用率、安全性和有效性;减少给药频率,方便用药:可有效释放新型的复合大分子药物:释放的药物浓度比较稳定,有效利用药物。Hsiue等[4]采用聚N-异丙酰胺水凝胶包载药物作成滴眼剂治疗青光眼,降压时间比普通制剂持久6倍。
目前,控释体系载体材料的研究方向主要是有机材料,如有机胶束,生物可降解高分子材料等。然而,与此同时,有机物在生物体中往往具有较差的化学和热稳定性。另外,它也很容易被免疫系统吞没,导致载体破裂而出现崩解释放等问题。
1.2靶向给药系统
理想的药物输送系统一方面需要实现定期,定量、定位的药物释放控制效果;另一方面,它需要能够将药物递送至患病组织,同时减少运输期间的泄漏。因此,在控制释放的基础上,需要实现肿瘤靶向。靶向给药的应用不仅可以提高药物对患病组织的治疗效果,还可以减少抗癌药物对正常组织的毒副作用。靶向药物递送系统通常使用肿瘤靶向性的导向分子(载体)来携带肿瘤治疗药物,这允许药物选择性地作用于患病组织。其中,靶向微纳米载体[5]系统使用纳米粒子,微粒,微球和微胶囊作为载体来封装或嵌入药物 ,这是近年来研究的热点之一,这是因为靶向微米/纳米颗粒载体系统具有改善药物吸收、控制药物释药速度、改变药物在身体中的分布和药代动力学性质并改善药物对肿瘤部位的靶向性的优点。
新的纳米级药物载体通常是几百纳米大小的小颗粒,纳米载体可分为有机和无机[6]。有机载体一般基于碳结构,其中大部分具有生物相容性的特点,可以增加载药量。主要的有机纳米载体是脂质体,胶束,基于蛋白质或多肽的纳米载体和树枝状聚合物。无机载体大多含有金属元素,同时,它们中的大多数尺寸较小并具有纳米级物理性质。
1.3光热治疗和光动力学治疗
此外,光热疗法(PTT)和光动力疗法(PDT)是近年来相对较新的肿瘤治疗方法。光热疗法是在近红外光照射下,使病灶组织内蓄积的光热转换材料吸收光能,将光能转化为热能,这可以增加肿瘤部位的温度以杀死肿瘤细胞。因此,光热疗法可以选择性地消除肿瘤组织,而不会对正常组织产生严重的副作用[7-8]。这使得光热疗法作为新开发的癌症治疗具有巨大的潜力。光动力治疗是另一种利用光能对抗肿瘤的新型治疗方法。主要原理是用适当的波长激发光敏剂产生活性氧(细胞毒性物质)来杀死肿瘤细胞以达到治疗的目的,而纳米级的光敏剂可被选择性吸收并聚集在肿瘤组织中。
光热转换材料CuS纳米粒子已成为纳米医学研究领域的一个新热点[9-13],因为它具有强大而稳定的光热转化能力,制备成本低,制备工艺简单。硫化铜纳米粒子作为新开发的光热转换材料,其主要特点是光热转换效率高,近红外吸收强,凭借此特性,可令硫化铜纳米粒子靶向至肿瘤。病变组织吸收了光能量之后温度逐渐升高,导致肿瘤组织发生热弹性膨胀。此外,CuS NPs也可以通过光催化作用进行光动力学治疗,铜离子可以与组织周围的含氧介质反应产生活性氧,从而杀死肿瘤细胞。因此,其作为光热转换材料,已经在肿瘤的诊断和治疗领域获得广泛关注。
1.4纳米硫化铜的合成方法研究
近年来,人们利用沉淀法、水热法 、固相法 、模板法等方法成功制备了硫化铜纳米材料。
沉淀法,在一定的反应条件下,在铜离子溶液中加入沉淀剂,产生沉淀。然后冲洗并去掉原料中的阴离子,最终干燥得到纳米硫化铜,该方法成本低,操作简便,设备和工艺简单,化学计量好。 Lim[14]以氯化铜和硫化钠为原料,采用直接沉淀法制备了CuS纳米溶胶。平均粒径为20-40nm,为规则的球形,粒度分布均匀,分散性良好。
水热法首先需要将水溶液或有机溶剂的反应体系加热至临界温度并在密闭反应器中产生高压环境,在这种环境下,不溶或不溶物质可以溶解并重结晶而进行无机合成。这种方法的特点是可得到发育完整的晶粒,均匀的粒度分布和较少的团聚,以及符合预期的化学计量组成。 Chen[15]等人使用CuSO 4和硫脲作为反应物在水热条件下合成硫化铜空心球24小时。谢等人。控制了水热条件下多孔CuS空心微球的制备。
固相法制备硫化铜,一般是通过研磨等作用下把研细后的铜盐和硫化物直接混合。这种固相化学反应可制得纳米硫化铜,该方法具有操作简单,工艺简便,避免或减少液相中易出现的硬团聚现象等优点。 Wang[16]等使用表面活性剂PEG400作为形态控制剂,并使用氯化铜(CuCl2·2H2O)和硫化钠(Na2S·9H2O)作为原料,通过在低温下的固态反应制备10.60nm直径和长度100 - 600纳米CuS纳米棒。
微波加热的方法采用分子运动加热,因此加热速度较快,温度梯度小。与传统的加热方式相比,易于实现系统的快速均匀加热,因而减小了传统加热方法中的温度和浓度梯度。另外,由于微波系统中分子的剧烈摩擦和碰撞,会加快核的形成并抑制晶粒的生长。从而微波加热制备的纳米材料具有粒径小,分布范围窄的特点。同时,微波炉具有温升迅速的特点。微波加热方式为内外一并加热,温度场均匀,可大大缩短干燥时间。由于微波干燥具有从内到外的干燥的特性,所以干燥材料首先从内层干燥,这可以克服在常规干燥中材料的外层首先被干燥以形成硬壳板的缺点。同时减小了材料在制备过程中颗粒长大以及团聚的可能性,从而更易得到有良好颗粒分散的粉末。
模板方法通常分为两个步骤,第一步使前体通过沉积或反应在模板表面形成核壳结构,在第二步中,通过加热,溶剂溶解等将模板消除以获得空心球结构。这种方法的关键是控制模板的形状,大小和易于移除。其特点是操作简单,形状可控,适用面广。刘金库[17]等人,以合成棉人造膜为模板,以硫酸铜和硫化钠为原料,有效地合成了膜组装体系中具有良好光学性能和规则形貌的CuS纳米球。
此外还有些较新颖的路线如微乳液 - 模板 - 界面反应路线。在这种方法中,有两个主要特征:首先两种反应物分别溶解在水包油(o / w)微乳液的两个不同相中,然后反应可在油/水界面发生。因此,可以成功获得空心球。然后,通过改变两相中的反应物,可以制备其他空心球。既不需要反应模板也不需要油滴界面与反应物之间的相互作用。微乳液滴作为纯模板。CuS空心球通过这种方法制造,通常使用环烷酸铜作为金属前体和硫代乙酰胺(TAA)作为硫源。
1.5纳米硫化铜的研究现状
然而HMCuS NPs这类裸露的中孔材料,普遍存在着缺乏有效的靶向能力和仍然过早的药物释放的问题。因此,目前许多研究在HMCuS NPs的基础上进行修饰以实现肿瘤靶向和受控的按需药物释放。
常见方法为进行封盖和结合配体。封盖可以起控释的作用,配体可以与肿瘤细胞表面特异性或过度表达的受体发生特异性反应,把药物靶向至肿瘤细胞,实现主动靶向释药,提高特定部位的药物浓度。常见的配体有维生素、蛋白质、多糖等[18]。
透明质酸(HA)是细胞外基质中的一种,是一种具有扩大的无规卷曲结构的高分子多糖[19]。此外,它可以被降解成小尺寸的片段,例如通过细胞内溶酶体酶透明质酸酶(HYAL-1),这是过度表达在肿瘤细胞中四糖。比较特别的是,透明质酸可以同时实现控释和靶向。一方面,可以选择HA作为肿瘤靶向部分来结合其在各种癌细胞上过度表达的CD44受体。另一方面,它也可以通过在中空纳米颗粒周围形成致密层来防止药物过早释出。除此之外,它还具有亲水性,封盖后将显着改善体系的稳定性和生物相容性[20]。Qian [21]等人使用透明质酸包封中空介孔硫化铜纳米粒,实验结果显示HMCuS-HA显着增强肿瘤部位的靶向和积聚能力。
转铁蛋白(Tf)也是一种有前景的配体,转铁蛋白(Tf)和在恶性组织中表达更多的转铁蛋白受体(TfR)发生相互作用。因此,可以把 Tf修饰在HMCuS NPs的表面上作为靶向分子。同时它还可以通过在HMCuS NPs周围形成致密层来起堵孔作用,负责减少过早药物释放。Lin[22]等人使用转铁蛋白修饰中空介孔硫化铜纳米粒,实验结果表明,Tf-HMCuS NPs可延长局部积累和滞留。
1.6 研究内容及意义
1.5.1 研究内容
本论文针对肿瘤药物存在的肿瘤靶向和控制释放的需求,以及有机质药物载体存在在生物体环境中易出现化学稳定性和热稳定性差等问题,设计合成HMCuS无机纳米载体。合成方法选用模板法,先以PVP-K30为分散剂,在碱性环境下,用水合肼把氯化铜还原成氧化亚铜纳米球,并以氧化亚铜为模板加入硫化剂合成HMCuS。后期对HMCuS的合成工艺进行优化以合成出粒径合适的HMCuS NPs载体材料,再对产品进行表征,并进行光学性能研究。
1.5.2 研究意义
本论文所研究的药物载体的优点为:
(1)HMCuS具有中空介孔结构,作为载体,其中空空腔可提高载药量,在装载药物后可实现控释,可实现定时定量地释放药物,在用合适的物质封盖后可起更好的控释作用
(2)HMCuS NPs可经过修饰后实现靶向。目前研究显示HMCuS可与较多种类的配体结合,构建成靶向给药系统。HMCuS带有较强的负电荷,可较方便地与一些带有正电性的配体,通过静电作用进行物理吸附。
(3)HMCuS具有光热转换能力较强的特性,可用于光热治疗和光动力学治疗。
第2章 HMCuS的制备、工艺优化及表征
2.1试剂及仪器
本制备过程用到的试剂及仪器见表2.1、表2.2。
表2.1 实验试剂
试剂名称 | 纯度 | 生产厂家 |
氯化铜 | 分析纯 | 国药集团化学试剂有限公司 |
PVP-k30 | 分析纯 | 国药集团化学试剂有限公司 |
水合肼 | 分析纯 | 国药集团化学试剂有限公司 |
氢氧化钠 | 分析纯 | 国药集团化学试剂有限公司 |
硫化钠 | 分析纯 | 上海凌峰化学试剂有限公司 |
硫代乙酰胺 | 分析纯 | 国药集团化学试剂有限公司 |
纯化水 | — |
仪器 | 型号规格 | 供应商 | |
冷冻干燥机 | LDGZ-25 | 宁波新芝生物科技股份有限公司 | |
pH试纸 | 范围(1-14) | 武汉医药集团化学试剂公司 | |
恒温磁力搅拌器 | CL85-2 | 常州溴华仪器有限公司 | |
纯水机 | PGR-5/10/20/30/40AU | 武汉品冠仪器设备有限公司 | |
循环水式多用真空泵 | SHB-Ⅲ | 杭州惠创仪器设备有限公司 | |
电子天平 | TP2007B | 上海卫凯仪器设备有限公司 | |
远红外高温干燥箱 | HWGZ-8130A | 上海精密实验设备有限公司 | |
超声仪 | CSY-12 | 上海卫凯仪器设备有限公司 | |
集热式恒温加热磁力搅拌器 | DF-101S | 河南省予华仪器有限公司 | |
油泵 | 2XZ-4 | 浙江台州求精真空泵有限公司 | |
表2.2 实验仪器
2.2试剂及仪器
以上是毕业论文大纲或资料介绍,该课题完整毕业论文、开题报告、任务书、程序设计、图纸设计等资料请添加微信获取,微信号:bysjorg。
相关图片展示: